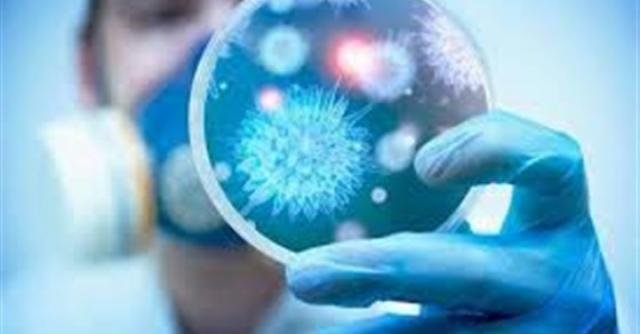

مذيع شهير يعلن إصابته بفيروس كورونا بعد خضوعه للحجر المنزلى
نشر المذيع الأمريكي أندي كوهين تعليقا عبر حسابه على موقع التواصل الاجتماعى انستجرام يعلن فيه عن اصابته بفيروس كورونا وذلك بعد ايام من خضوعه للحجر المنزلى.
وقال أندي كوهين : "بعد بضعة أيام من الحجر الصحي الذاتي ، وشعوري بالتعب أثبتت الفحوصات إصابتي بفيروس كورونا .. وبقدر ما كنت متحمسا لتقديم برنامج Watch What Happens Live عبر الانترنت بقدر ما أشعر بخيبة أمل لتوقفه وتركيزي حاليا على تحسن حالتي الصحية ".
وأضاف "أوجه الشكر للأطباء الذي يعملون بلا كلل من أجلنا جميعا ، وأحث الجميع على البقاء في المنزل".
يذكر ان فيروس كورونا اصاب عددا من النجوم العالميين منهم توم هانكس وادريس البا وبطلة مسلسل "Game of Thrones".
